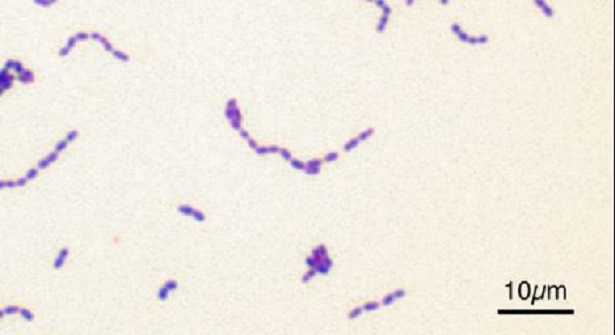
Streptococcus agalactiae Streptococcus agalactiae

Non si parla di cose gravi quando si nomina il Streptococcus agalactiae ma è interessante sapere di cosa si tratta e come di prende, anche perché è molto temuto dalle donne in stato di gravidanza. Questo battere è gram-positivo e appartiene al microbiota umano, si potrebbe definire un colonizzatore innocuo che possiamo trovare nell’uomo, a livello gastrointestinale e uro-genitale.
Abbiamo detto che è abbastanza innocuo ed in effetti non è un batterie da allarme rosso ma ciò non esclude il fatto che in alcuni casi può diventare patogeno e dare origini a delle sgradite infezioni. Ecco perché chi aspetta un bambino lo teme. Un altro nome con cui è conosciuto è quello di streptococco beta-emolitico, sta ad indicare in ogni caso una specie di batteri che presenta una serie di categorie. Esistono infatti ben dieci sierotipi che si differenziano per il tipo di antigeni presenti sulla capsula batterica.
Streptococcus agalactiae: come agisce
Questo streptococco si dispone a coppie e preferisce operare in condizioni di anaerobiosi. Il nome di “beta-emolitico” del gruppo B si spiega con il fatto che questo battere è in grado di provocare la completa distruzione dei globuli rossi in terreni di coltura agar-sangue.
Lo streptococco agalactiae, considerato quasi sempre innocuo, è presente nel tratto gastrointestinale, rettale e uro-genitale del 30% circa degli individui sani, sia di sesso femminile che di sesso maschile.
Sono pochi, ma esistono, i casi in cui diventa pericoloso e quando capita può causare delle infezioni, anche gravi. Tra tutti i sierotipi ce ne sono alcuni più potenzialmente pericolosi come ad esempio il sierotipo III che è legato all’insorgenza di infezioni neonatali che provocano meningite.
Streptococcus agalactiae: come si prende
Quando questo Streptococcus agalactiae diventa pericoloso sfocia in problemi piuttosto seri e che se non siamo degli esperti, difficilmente li collegheremmo a questo apparentemente innocui battere. Mi riferisco ad esempio a polmonite, endometrite, amnionite, batteriemia, patologie infettive del tratto urinario e meningite.
A tutte le età è possibile che si presentino queste patologie, non c’è un sesso più a rischio dell’altro, ma ci sono delle categorie che sono maggiormente esposte. Ad esempio i neonati e le donne in stato di gravidanza. In entrambi i casi le conseguenze possono essere davvero gravi. Una donna incinta, a causa di una infezione del genere trascurata, può riportare anche dei danni al feto. I neonati che registrano delle infezioni da streptococco agalactiae rischiano la vita e possono soffrire di meningiti, polmoniti e batteriemie.
Come si può trasmettere un’infezione del genere? I neonati molto spesso la prendono dalla madre, durante il parto, mentre gli adulti molto probabilmente attraverso i rapporti sessuali non protetti ma è una informazione che deve essere confermata da ulteriori studi.

Streptococcus agalactiae: cura
Una infezione del genere deve essere assolutamente trattata con dei farmaci antibiotici. Non è nostro compito prescriverli ma possiamo fare i nomi di quelli che ad oggi sono i prodotti più usati. Le cefalosporine come la cefotaxima, le penicilline come la benzilpenicillina e l’ampicillina, adatta soprattutto per i neonati, e poi i macrolidi come l’azitromicina, la claritromicina e l’eritromicina.
Chi è un po’ esperto si ricorderà questo nome, macrolidi, utilizzato anche in un altro contesto. Le stesse sostanze consigliate qui, infatti, possono essere impiegate anche per pazienti che hanno un’allergia agli antibiotici beta-lattamici, quali sono le penicilline e le cefalosporine. Se a contratte l’infezione è una donna in stato di gravidanza, non basta seguire una terapia antibiotica, è necessario fare di più per evitare che il futuro nato sia danneggiato.
La donna deve quindi sottoporsi ad una profilassi antibiotica per via endovenosa durante il travaglio.
Streptococcus agalactiae e animali
Non sempre capita che i batteri che creano problemi agli uomini siano dannosi anche per gli animali ma in questo caso è proprio così che funziona. In particolare possiamo concentrare la nostra attenzione sulle mucche. Il Streptococcus agalactiae può essere il responsabile dell’insorgenza di mastiti nelle mucche da latte. Il povero animale diventa quindi vittima di una febbre acuta che porta a una ridotta sintesi di latte da parte dell’animale.
Altri animali che possono restare infettati da questo battere sono cani, gatti, cammelli, foche, delfini e perfino coccodrilli. Tra le vittime ci sono anche i pesci, si vedono anche delle vere e proprie epidemie.
Se vi è piaciuto questo articolo continuate a seguirmi anche su Twitter, Facebook e Instagram
